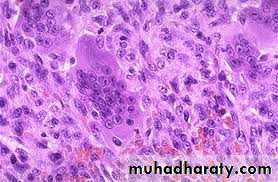

بسم الله الرحمن الرحيم
1
12 December 2015
Bone tumor
212 December 2015
Benign
Source of originmalignant
Osteoma
Arise from bone
osteosarcoma
Osteoid osteoma
OsteoblastomaGiant cell tumor
EnchondromaArising from cartilage
chondrosarcoma
OsteochondromaChondromyxoid fibroma
chondroblastoma3
12 December 2015
Fibrous cortical defect
From fibrous tissueMalignant fibrous histiocytoma (MFH)
Non-ossifying fibromaFibrous dysplasia
Simple bone cystUncertain origin
Ewing's sarcoma
Aneurysmal bone cystadmantinoma
412 December 2015
QUESTIONS TO ASK WHEN STUDYING ANX-RAY
5
12 December 2015
is the lesion solitary or are there multiple lesions?
What type of bone is involved?Where is the lesion in the bone?
Are the margins of the lesion well- or ill-defined?6
12 December 2015
Are there flecks of calcification in the lesion?
is the cortex eroded or destroyed?is there any periosteal new-bone
formation?Does the tumour extend into the soft tissues?
7
12 December 2015
8
12 December 2015
9
12 December 2015
This is a benign circumscribed lesion that may arise from the cortex of long bones or occasionally from the cancellous bone of the spine.
Affect young patients 10-35 years.
3 times common in males than females.
Osteoid osteoma
10
12 December 2015
The characeristic features is the formation of a small nidus of osteoid tissue usually less than 0.5cm diameter, surrounded by a reactive zone of dense sclerotic new bone formation.
Pathology
11
12 December 2015
Usually present with increasingly sever but well - localised ,deep aching pain and sometimes local bone tenderness.
Pain worse at night.
Eased by aspirin or NSAIDS.
( Diagnostic features) .
Clinical features
12
12 December 2015
Plain x-ray
Show local sclerotic thickening of the shaft that may obscure the small central nidus within the area of rarefaction.The nidus is best seen on a fine cut CT scan
Intense uptake on an isotope bone scan.
Imaging13
12 December 2015
C T scan
1412 December 2015
May resolve spontaneously after several months.
Most require surgeryRemoval of the nidus alone produce dramatic relieve and this done by,
Surgical exscion,
curettage.
CT guided needle can be inserted into the nidus and the lesion ablated with radiofrequency coagulation.
Treatment
15
12 December 2015
16
12 December 2015
17
12 December 2015
OSTEOCHONDROMA (CARTILAGE-CAPPEDEXOSTOSIS)
18
12 December 2015
This, one of the commonest ‘tumours’ of bone, is a developmental lesion which starts as a small over-growth of cartilage at the edge of the physeal plate.
And develops by endochondral ossification into a bony pro-tuberance still covered by the cap of cartilage.
19
12 December 2015
commonest sites are the fast-growing ends of long bone.
and the crest of the ilium.20
12 December 2015
The patient is usually a teenager or young adult
when the lump is first discovered.Occasionally there is pain due to an overlying bursa or impingement on soft tissues,
or, rarely, paraesthesia due to stretching of an adjacent nerve.
Clinical features
21
12 December 2015
22
12 December 2015
23
12 December 2015
the cartilage cap is seen surmounting a narrow base or pedicle of bone.
The cap consists of simple hyaline cartilage;in a growing exostosis the deeper cartilage cells are arranged in
columns, giving rise to the formation of endochondral new bone.
Pathology
24
12 December 2015
is pathognomonic. There is a
well-defined exostosis emerging from the metaphysis,its base co-extensive with the parent bone.
It looks smaller than it feels because the cartilage cap is usually invisible on x-ray.
The x-ray appearance
25
12 December 2015
26
12 December 2015
27
12 December 2015
28
12 December 2015
Multiple lesions may develop as part of a heritable disorder – hereditary multiple exostosis .
Ollier disease
29
12 December 2015
Large lesions may have a ‘cauliflower’
appearance, with degeneration and calcification in the Centre of the cartilage cap.30
12 December 2015
The incidence of malignant transformation is difficult to assess .
Complications31
12 December 2015
If the tumour causes symptoms it should
be excised; if, in an adult, it has recently become bigger or painful then operation is urgent.Treatment
32
12 December 2015
33
12 December 2015
GIANT-CELL TUMOURosteoclastoma
3412 December 2015
Giant-cell tumour, which represents 5 per cent of all primary bone tumours.
most commonly in thedistal femur,
proximal tibia,
proximal humerus .
and distal radius.
though other bones also may be affected.
Pathology
3512 December 2015
It is hardly ever seen before closure of the nearby physis .
and 10% behaves as malignant .
characteristically it extends right up to the subarticular bone plate.Rarely, there are multiple lesions.
3612 December 2015
Tumor consist abundant of mononuclear stromal cells profusely interspersed with giant cell.
Histologically
37
12 December 2015
38
12 December 2015
The patient is usually a young adult 20-40 years who complains pain at the end of a long bone;
sometimes there is slight swelling.
A history of trauma is not uncommon.
Some time the patient is made suddenly aware of some thing wrong.
Clinical features39
12 December 2015
40
12 December 2015
41
12 December 2015
show a radiolucent area situated eccentrically at the end of a long bone and bounded by the sub- chondral bone plate.
The endosteal margin may be quite obvious, but in aggressive lesions it is ill-defined.
X-rays42
12 December 2015
The Centre sometimes has a soap-bubble appearance.
The cortex is thin and sometimes ballooned. aggressive lesions extend into the soft tissue.43
12 December 2015
The appearance of a ‘cystic’ lesion in mature bone, extending right up to the subchondral plate, is so characteristic
44
12 December 2015
blood calcium, phosphate and alkaline phosphatase concentrations so as exclude an
unusual ‘brown tumour’ associated with hyper parathyroidism.Other investigations
45
12 December 2015
CT scans and MRI will reveal the extent of the tumour, both within the bone and beyond.
46
12 December 2015
Is essential. This can be done either as a
frozen section before proceeding with operative treatment or(especially if a more extensive operation is contemplated) as a separate procedure
Biopsy
47
12 December 2015
Well-confined, slow-growing lesions with benign histology can safely be treated by thorough curettage and ‘stripping’ of the cavity with burrs and gouges,
followed by swabbing with hydrogen peroxide or by the application of liquid nitrogen;
the cavity is then packed with bone chips.
Recurrence about 20-25%Treatment
48
12 December 2015
Some time the cavity occupied with bone cement (methyl methacrylate)which
is acting through its exothermic action andmechanical supports to the subchondral bone and cartilage.
49
12 December 2015
More aggressive tumours, and recurrent lesions, should be treated by excision followed,
if necessary, by bone grafting or
prosthetic replacement.
5012 December 2015
51
12 December 2015
Tumours in awkward sites
(e.g. the spine) may be difficult to eradicate; supplementary radiotherapy is sometimes recommended.52
12 December 2015
but it carries a significant risk of causing malignant transformation
5312 December 2015
54
12 December 2015
ANEURYSMAL BONE CYST
aneurysmal bone cyst may be encountered at any age and in almost any bone, though more often in young adults.Below 20 years age in 75%.
25% in spine.
20% long bones.
in the long-bone metaphysis.
Usually it arises spontaneously but it may appear after degeneration or haemorrhage in some other lesion.
55
12 December 2015
With expanding lesions, patients may complain of pain.
Occasionally, a large cyst may cause a visible or palpable swelling of the bone.
5612 December 2015
Histology
Characteristic findings• cavernous space
• blood-filled spaces without endothelial lining
• cavity lining
• numerous benign giant cells
• spindle cells
• thin strands of bone present in fibrous tissue of septae
12 December 2015
57
X-rays
show a well-defined radiolucent cyst, often trabeculated and eccentrically placed.In a growing tubular bone it is always situated in the metaphysis
and therefore may resemble a simple cyst or one of the other cyst-like lesions.
58
12 December 2015
•MRI or CT scan ◦will show multiple fluid lines
•Bone scan ◦is warm to hot12 December 2015
59Occasional sites include vertebrae.
and the flat bones.In an adult an aneurysmal bone cyst may be mistaken
for a giant-cell tumour
Chondroblastoma
Osteoblastoma
osteosarcoma
60
12 December 2015
Pathology
When the cyst is opened it is found to contain clotted blood, and during curettage there may beconsiderable bleeding from the fleshy lining membrane.
61
12 December 2015
the lining consists of fibrous tissue with vascular spaces, deposits of haemosiderin and multinucleated giant cells.
Occasionally the appearances so closely resemble those of giant-cell tumour
Histologically
6212 December 2015
Treatment
The cyst should be carefully opened, thoroughly curetted and then packed with bone grafts.Sometimes the graft is resorbed and the cyst recurs
necessitating a second or third operation.In these cases, packing with methyl methacrylate cement may be more effective.
63
12 December 2015
OSTEOSARCOMA}
12 December 201564
Osteosarcoma
highly malignant tumour arising within the bone andspreading rapidly outwards to the periosteum and surrounding soft tissues. It is said to occur predominantly
in children and adolescents, 10-25 years
may affect any bone but most commonly involves the
long-bone metaphysis, especially around the knee andat the proximal end of the humerus.
The tumour extends
Within the medulla and across the physeal plate.Obvious spread into the soft tissues with ossification at the periosteal margins and streaks of new
Bone extending into the extraosseous mass.
Pathology
Pain is usually the first symptom; it is constant,
Worse at night and gradually increases in severity.Sometimes the patient presents with a lump.
Pathological fracture is rare.
CLINICAL FEATURES
On examination
there may be little to findexcept local tenderness.
In later cases there is a palpable mass and the overlying tissues may appear swollen and inflamed.
The over lying skin warmer than normal because of its vascularity.
The skin also shiny and stretched.
INVESTIGATIONS
The ESR is usually raised and there may bean increase in serum alkaline phosphatase.
X-rays
variable hazy osteolytic .
areas may alternate with unusually dense Osteoblastic areas.The endosteal margin is poorly defined. often
The cortex is breached .
The tumour extends into the adjacent tissues; when this happens.
Streaks of new bone appear, radiating outwards from the cortex – the so-called ‘sunburst’ effect.Reactive new bone forms at the angles of periosteal elevation (Codman’s triangle).
MRI
Allow accurate delination of the tumor size and the extent of invasion to the near soft tissue.
Radioactive isotops
Increased uptake.
And the extension in to the medullary canal (skipped lesion).CT and chest radiograph is mandatory for preoperative staging
Treatment
The patient is admitted to a special center for biopsy.The lesion will probably be graded IIA or IIB.
Multi-agent neoadjuvant chemotherapy is given for 8–12 weeks and then.
Provided the tumor is resectable and there are no skip lesions, a wide resection is carried.
Replace that segment of bone with either a large bone graft or a custom-made implant;
in some cases an amputation may be
more appropriate.The specimen is examined to assess the response to preoperative chemotherapy.
If tumour necrosis is marked (more than 90 per cent),Chemotherapy is continued for another 6–12 months;
If the response is poor, a different chemotherapeutic regime is substituted.
EWING SARCOMA
12 December 201589
Ewing’s sarcoma
is believed to arise from endothelial cells in the bone marrow.It occurs most commonly
between the ages of 10 and 20 years.
usually in a tubular bone and especially in the
tibia, fibula or
clavicle.
Pathology
Macroscopically the tumour is lobulated.
It may look grey (like brain) or red
(like redcurrant jelly) if haemorrhage has occurred into it.
Microscopically, sheets of small dark polyhedral cells with no regular arrangement and no ground substance are seen.
CLINICAL FEATURES
The patient presents with pain – often throbbing in character .
swelling.Generalized illness .
pyrexia, together with
a warm, tender swelling and.
a raised ESR, may suggest a diagnosis of osteomyelitis.
X-rays usually show an area of bone destruction
in the mid-diaphysis.New bone formation may appears as fusiform layers of bone around the lesion – the so-called ‘onion-peel’ effect.
Imaging
Infiltration into the surrounding soft tissues, with radiating streaks of ossification and reactive periosteal bone at the proximal and distal margins. These features (the‘sunray’ appearance and Codman’s triangles)
CT and MRI reveal the large extra osseous component.
Radioisotope scans may show multiple areas of activity in the skeleton.
DiagnosisThe condition which should be excluded as rapidly as possible is:
bone infection.
reticulum-cell sarcoma .
and metastatic neuroblastoma.
Treatment
Radiotherapy has a dramatic effect.
Chemotherapy is much more effective,5-year survival rate of about 50 %.
The best results are achieved by a combination of
all three methods.a course of preoperative neoadjuvant chemotherapy; then wide excision .
or radiotherapy followed by local excision if it is less accessible; and then a further course of chemotherapy for 1 year.
SIMPLE BONE CYST
also known as a solitary cyst or unicameral bone cyst) appears during childhood, typically in themetaphysis of one of the long bones and most commonly in the proximal humerus or femur.
Pathology
The lining membrane consists of flimsy fibrous tissue, often containing giant cells. In anactively growing cyst, there is osteoclastic resorption of the adjacent bone.
Clinical features
The condition is usually discovered after a pathological fracture or as an incidental finding on x-ray.
it tends to heal spontaneously and it is seldom seen in adults.
X-raysshow a well-demarcated radiolucent area in
the metaphysis, often extending up to the physeal plate.the cortex may be thinned and the bone expanded.
DD
Non-osteogenic fibroma,
fibrous dysplasia .
benign cartilage tumours are solid and merely look cystic on x-ray.
Treatment
Treatment depends on whether the cyst issymptomatic,
actively growing or involved in a fracture.
Asymptomatic lesions in older children can be left alone.
Active’ cysts
usually abutting against the physeal plate and obviously enlarging in sequential x-rays.
should be treated, in the first instance, by aspiration of fluid and injection of 80–160 mg of methylprednisolone.
or autogenous bone marrow.
This often stops further enlargement and leads to healing of the cyst.
If the cyst goes on enlarging or if there is a pathological fracture.
the cavity should be thoroughly cleaned by curettage and then packed with bone chips.METASTATIC BONE DISEASE
The skeleton is one of the commonest sites of secondary cancer;in patients over 50 years bone metastases are seen more frequently than all primary malignant bone tumours together.
The commonest source
is carcinoma of the breast;
prostate,
kidney,
lung,
thyroid,
bladder and
gastrointestinal tract.
In about 10 per cent of cases no primary tumour is found.
For bone metastases are thecommonest sites
Vertebrae,pelvis,
proximal half of the femur and
humerus.
Spread is usually via the blood stream;
occasionally, visceral tumours spread directly to adjacent bones (e.g. the pelvis or ribs).
Metastases are usually osteolytic,
and pathological fractures are common.Bone resorption is due either to the direct action of tumour cells or to tumour-derived factors that stimulate osteoclastic activity.
Osteoblastic lesions are uncommon; they usually occur in prostatic carcinoma.
Clinical features
The patient is usually aged50–70 years;
with any destructive bone lesion in this age group, the differential diagnosis must include metastasis.
Pain is the commonest – and often the only – clinical feature.
The sudden appearance of backache orhigh pain in an elderly person (especially some one to have been treated for carcinoma in the past). always suspicious. If x-rays do not show anything.
Some deposits remain clinically silent and are
discovered incidentally on x-ray examination or bone scanning.or after a pathological fracture. Sudden collapse of a vertebral body .
or a fracture of the mid-shaft of a long bone in an elderly person are ominous signs;Symptoms of hypercalcaemia may occur .
often missed in patients with skeletal metastases
These include anorexia, nausea, thirst, polyuria
In children under 6 years of age, metastatic lesions are most commonly from adrenal neuroblastoma.
The child presents with bone pain and fever;
Examination reveals the abdominal mass.Imaging
Most skeletal deposits are osteolytic and appear as rarified areas in the medullaor
produce a moth-eaten appearance in the cortex.
sometimes there is marked bone destruction, with or without a pathological fracture.
Osteoblastic deposits suggest a prostatic carcinoma; the pelvis may show a mottled increase in density which has to be distinguished from
Paget’s disease
Or
lymphoma.
Radioscintigraphy
Bone scans with 99mTc-MDP are themost sensitive method of detecting ‘silent’ metastatic
deposits in bone; areas of increased activity are selected for x-ray examination.
Special investigations
The ESR may be increased and thehaemoglobin con- centration is usually low.
The serum alkaline phosphatase concentration is often increased, and in
acid phosphatase also is elevated.
Patients with breast cancer can be screened by measuring blood levels of tumour-associated antigen markers.
Treatment
By the time a patient has developed secondary deposits the prognosis for survival is poor.